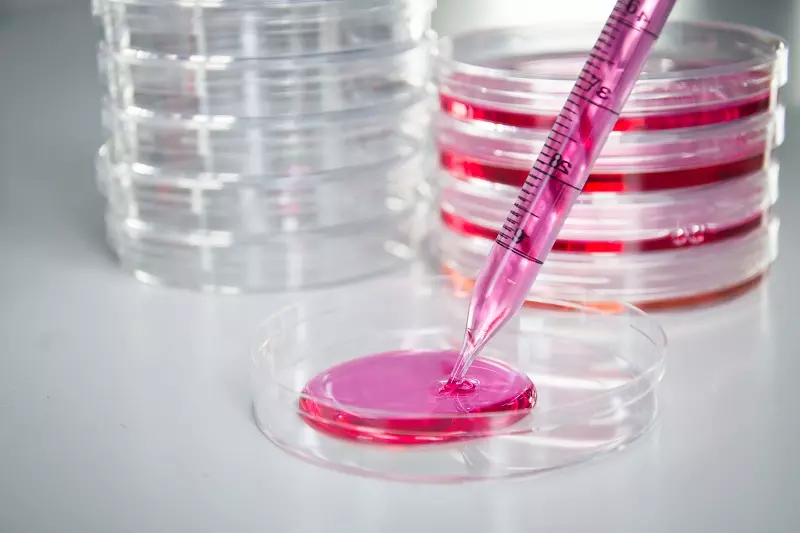

Des chercheurs de l’Université de Stanford annoncent avoir régénéré la mémoire et les capacités d’apprentissage de souris âgées en injectant dans leur cerveau des protéines provenant du sang de cordon ombilical humain.
Leur découverte serait-elle dans le futur applicable sur l’homme ?

Une étude scientifique menée sur les souris âgées
Une équipe de scientifiques de l’Université de Stanford explique que des propriétés dans le sang ombilical pourraient un jour être utilisées pour ralentir la dégénérescence neurologique dans le cerveau humain.
Au cours de leur étude, les chercheurs ont recueilli des échantillons de sang humain à trois stades différents (du cordon ombilical de bébés, de jeunes âgés entre 19 et 24 ans et de personnes entre 61 et 82 ans).
Par la suite, ils ont injecté les semences prélevées chez des souris âgées d’environ 12 mois et ont analysé leur comportement.
Le sang ombilical ralentirait la dégénérescence neurologique chez les souris
Résultats : les souris ayant reçu le plasma du sang provenant du cordon ombilical ont vu leur mémoire vivifiée et leurs souvenirs améliorés.
Résultats : les souris ayant reçu le plasma du sang provenant du cordon ombilical ont vu leur mémoire vivifiée et leurs souvenirs améliorés.
Au niveau cellulaire, les chercheurs ont également constaté une activité accrue dans l’hippocampe, l’une des premières régions à se détériorer avec l’âge.
Notons que des résultats similaires, mais moins impressionnants ont été observés dans le groupe de souris ayant reçu le plasma sanguin des jeunes adultes (19-24 ans) et qu’aucune amélioration n’a été observée chez les souris traitées avec le sang des personnes âgées.
Source
Cet article a été publié par la Rédaction le



